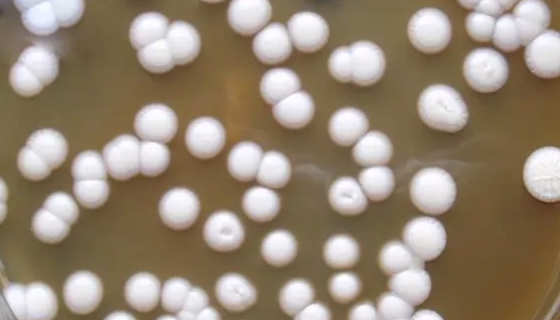
拟多形假丝酵母的保存方法与微生物菌种培养！
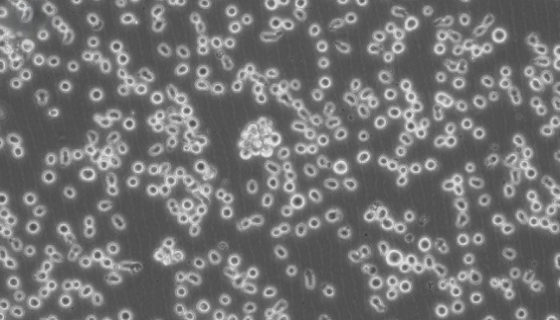
人慢性骨髓性白血病细胞系的培养操作步骤！
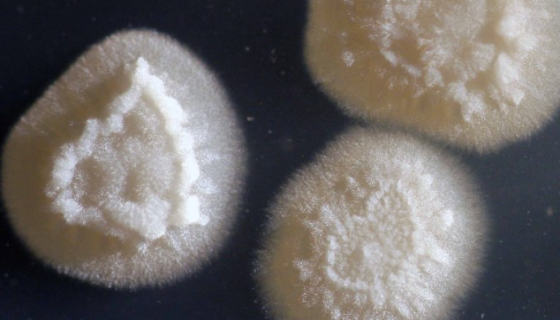
ATCC 20177 解脂耶氏酵母的特点与优势及培养！
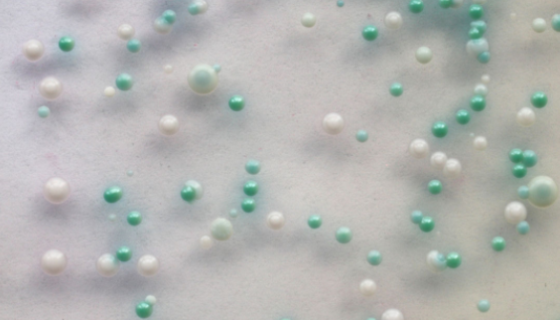
ATCC 22019 近平滑假丝酵母（近平滑念珠菌）

拟多形假丝酵母的保存方法与微生物菌种培养!
拟多形假丝酵母,属能形成假菌丝、不产生子囊孢子的酵母。不少的...

人NK细胞淋巴瘤细胞的处理方法与培养步骤!
人NK细胞淋巴瘤细胞收到后的处理方法与培养步骤及注意事项有哪...

ATCC 16451 嗜热毛壳菌 百欧博伟生物
嗜热毛壳,属毛壳目,毛壳科,拉丁名为Chaetomium t...

ATCC13032 谷氨酸棒状杆菌冻干管打管说明!
谷氨酸棒状杆菌(Corynebacterium glutam...
人慢性骨髓性白血病细胞系的培养操作步骤!
人慢性骨髓性白血病细胞系是一种具有多向分化潜能的造血系统的恶...

比格犬软骨细胞的运输和保存及使用与注意事项!
软骨细胞存在于关节软骨中,负责分泌II型胶原和其它类型的胶原...

铅黄肠球菌的培养条件与注意事项及打管说明!
铅黄肠球菌,肠球菌属,细胞球形或卵圆形。不生芽孢。革兰氏阳性...
ATCC 20177 解脂耶氏酵母的特点与优势及培养!
解脂耶氏酵母是Yarrowia属的微生物,原产地为中国。主要...
ATCC 22019 近平滑假丝酵母(近平滑念珠菌)
近平滑假丝酵母(近平滑念珠菌)仅用于科学研究或者工业应用等非...